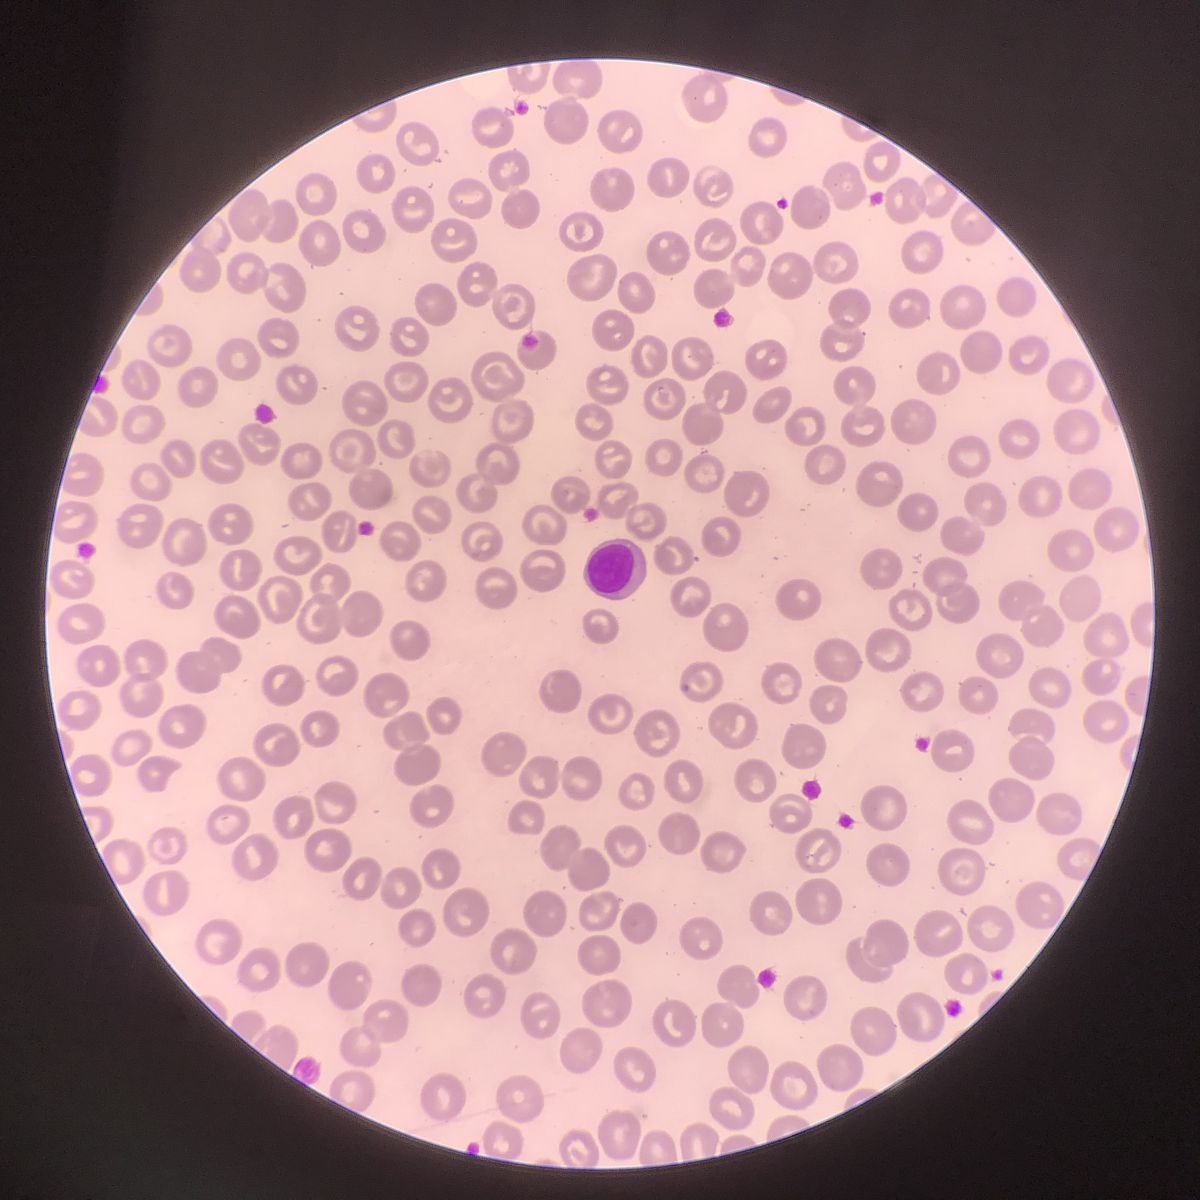
淋巴细胞降低，嗜酸性粒细胞降低，并且发烧

淋巴细胞降低,嗜酸性粒细胞降低,并且发烧
这些症状可能提示身体正在经历一次感染。淋巴细胞和嗜酸性粒细胞是身体的免疫系统的一部分,它们帮助对抗病原体。如果它们的数量下降,那么身体就更容易受到感染的威胁。发热也是身体对抗感染的一种反应。建议及时就医,进行相关检查和治疗。

原文地址: https://www.cveoy.top/t/topic/uVm 著作权归作者所有。请勿转载和采集!
安全问答是一个知识全球问答,包含丰富的问答知识
这些症状可能提示身体正在经历一次感染。淋巴细胞和嗜酸性粒细胞是身体的免疫系统的一部分,它们帮助对抗病原体。如果它们的数量下降,那么身体就更容易受到感染的威胁。发热也是身体对抗感染的一种反应。建议及时就医,进行相关检查和治疗。
原文地址: https://www.cveoy.top/t/topic/uVm 著作权归作者所有。请勿转载和采集!